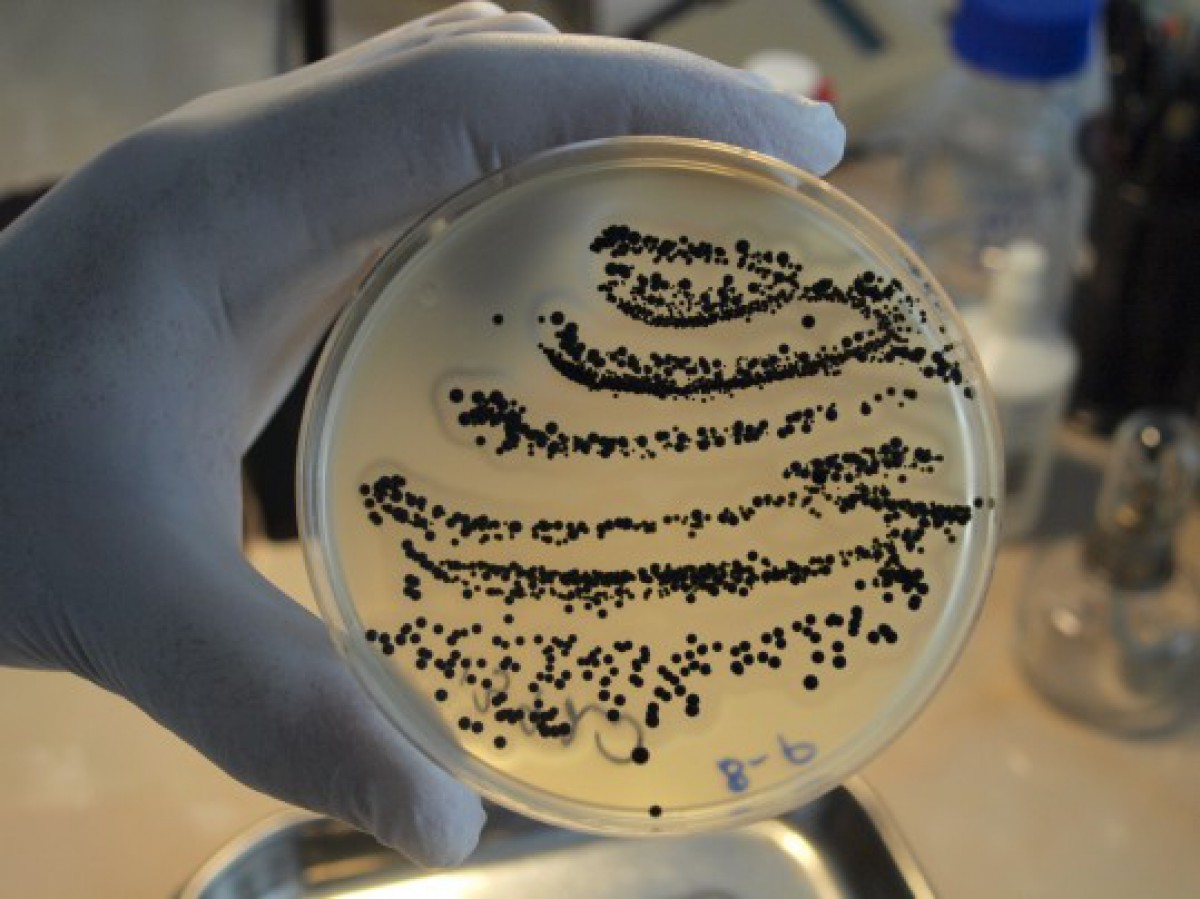

«Ventas Balss» pētījums: kas dzīvo uz banknotēm? (VIDEO/FOTO)
13. marts, 16:02, 2014
|
Zarnu nūjiņas, stafilokoks, salmonella, gripa un daudzas, daudzas citas baktērijas dzīvo uz naudas. Banknotes šajā reitingā apsteigušas tādas baktēriju šķietami apsēstas lietas kā durvju rokturi, margas sabiedriskās vietās, bankomātu pogas.
Oksfordas zinātnieki noskaidrojuši, ka uz vienas banknotes atrodas vidēji 26 000 baktēriju. Vistīrākie izrādījās eiro – vidēji 11000 baktēriju, netīrākas bija dāņu koronas, Šveices franki un Krievijas rubļi.















Komentāri (0)